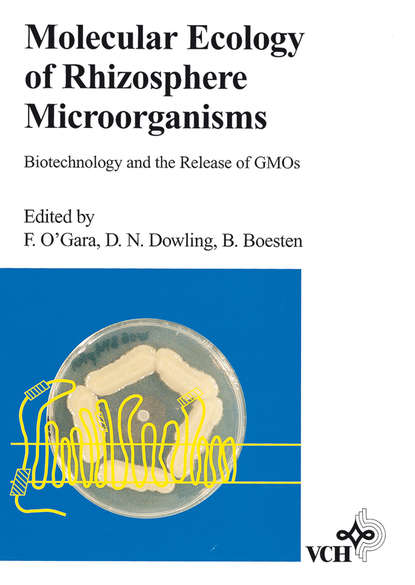
Molecular Ecology of Rhizosphere Microorganisms

Molecular Ecology of Rhizosphere Microorganisms
This book helps evaluate the state of the art of rhizosphere microbial ecology and biotechnology. Experts in the field review methods and strategies applied to the detection, identification and monitoring of microorganisms in the rhizosphere. Major topics treated include: – construction of genetically marked rhizosphere bacteria – detection of marked wildtype and genetically modified organisms (GMOs) – identification of wildtype and GMOs by DNA probes and PCR amplification – rapid typing of non-modified and GMOs by PCR-based techniques – assessment of the role of gene transfer – EU regulations for the use and release of GMOs – biosafety results from field testing of GMOs In addition, technologies for the modifying gene expression and gene products for specific traits of agronomic interest in genetically engineered rhizosphere bacteria are covered.